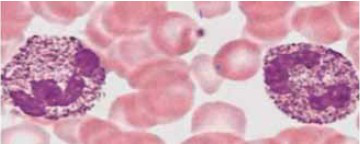
Enunciado 3417867-1

Foram encontradas 590 questões.
A contagem total de leucócitos no líquido cefalorraquidiano (LCR) representa o parâmetro mais sensível para caracterização de uma doença inflamatória do sistema nervoso central (SNC). Identificar o tipo ou tipos de células presentes no LCR é uma valiosa ferramenta diagnóstica, pois, conforme a linhagem celular predominante nessa contagem, é possível se estabelecer uma conduta terapêutica adequada de acordo com o significado clínico desse resultado laboratorial. Quadros de linfocitose no LCR são observados em casos de
Provas
A cariotipagem é uma metodologia que analisa células de um indivíduo para determinar seu padrão cromossômico. A análise cromossômica de uma criança do sexo feminino com alterações morfológicas apresentou fórmula cariotípica 45, X0. A alteração cromossômica da criança indica:
Provas
Paciente masculino, 23 anos, chegou ao Pronto-Socorro apresentando queixa de dores no hipocôndrio direito com confirmação de aumento de volume do órgão, linfonodos aumentados na região do pescoço e virilhas. Presença de febre baixa e duas discretas erupções cutâneas. Em exames realizados na urgência, o hemograma apresentou um quadro de celularidade de mononucleares atípicos com linfocitose de 87% dentre 13 000 leucócitos/mm3. Para o diagnóstico diferencial, recomenda-se a execução de sorologia para:
Provas
Paciente infantil, diagnosticado com mucopolissacaridose (MPS) tipo IV apresentou em seu hemograma: índice leucocitários sem alterações e presença de alterações neutrofílicas. O exame citoquímico demonstrou acentuado acúmulo de sulfato de heparan, como demonstra a figura a seguir.
Lâmina de esfregaço de sangue periférico:
(Laboratório de Análises Clínicas da FMABC)
Estas alterações neutrofílicas recebem o nome de
Provas
A hemofilia é uma doença hemorrágica hereditária caracterizada pela deficiência das proteínas conhecidas como fatores VIII (hemoflia A) e IX (hemoflia B). Em caso de suspeita médica, o diagnóstico laboratorial das hemofilias A e B inicia-se com quais exames?
Provas
De acordo com o SINAN Online (Sistema de Informação de Agravos de Notificação) até a semana epidemiológica (SE) 48 ocorreram 508.212 casos prováveis (taxa de incidência de 238,2 casos por 100 mil hab./2021) de dengue no Brasil, sendo ainda hoje a principal arbovirose tropical em termos de morbidade e mortalidade. Em relação ao diagnóstico nosológico de teste rápido imunocromatográfico de antígeno NS1, deve ser interpretado corretamente da seguinte forma:
Provas
O líquido cefalorraquidiano (LCR) é um líquido incolor, que circula o cérebro e a medula espinhal através do espaço subaracnóideo, ventrículos cerebrais e o canal central da medula. Dentre as funções que o LCR desempenha, podemos citar:
Provas
As infecções ocasionadas pelos microrganismos do conjunto Mycobacterium tuberculosis, na maioria dos hospedeiros, encontram-se na forma latente, podendo, de acordo com a Organização Mundial de Saúde, recidivar a forma contagiosa. Portanto, a identificação dos indivíduos portadores de tuberculose latente tem fundamental importância nas estratégias de eliminação da tuberculose. Sobre o teste IGRA (Interferon Gama Release Assay), assinale a alternativa correta.
Provas
Um paciente com bronquite crônica, tabagista de 20 cigarros/ dia por 30 anos, iniciou tratamento com nicotina transdérmica 21 mg há 2 semanas. O médico, então, decide iniciar com bupropiona 150 mg ao dia.
Assinale a alternativa que apresenta o sintoma que pode estar relacionado ao uso da bupropiona.
Provas
Qual dos seguintes pacientes requer colonoscopia antes de fazer o diagnóstico de síndrome do intestino irritável?
Provas
Caderno Container